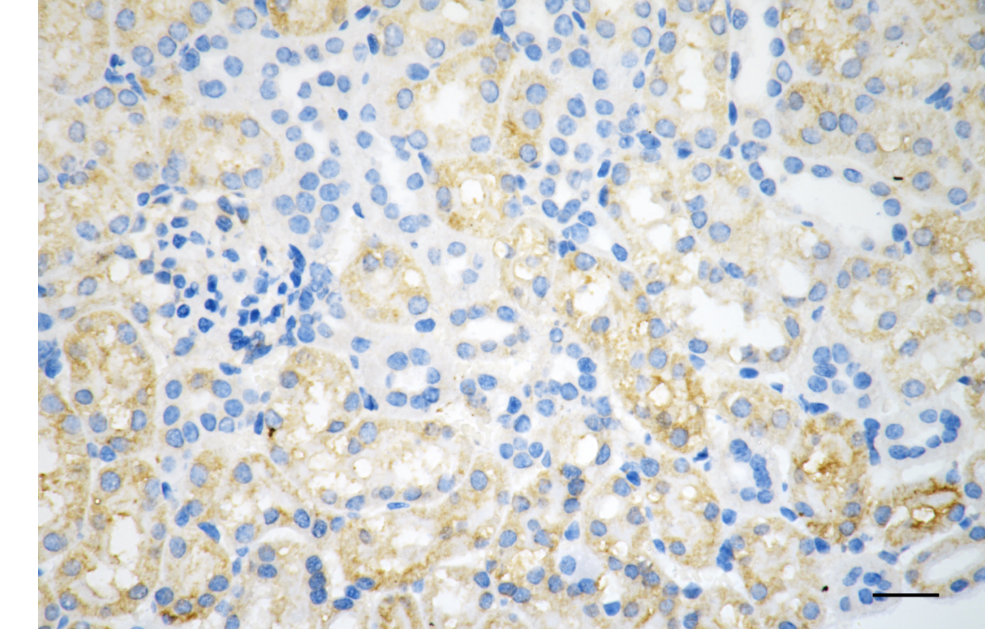

-
中文名稱:ITGAV Recombinant Monoclonal Antibody
-
貨號:CSB-RA924592A0HU
-
規格:¥1320
-
圖片:
-
Flow cytometric analysis of Integrin subunit alpha V expression in HeLa cells using Integrin subunit alpha V antibody. Green, isotype control; red, Integrin subunit alpha V.
-
Immunocytochemical staining of HeLa cells with ITGAV antibody. Nuclei were stained blue with DAPI; ITGAV was stained magenta with Alexa Fluor? 647. Images were taken using Leica stellaris 5. Protein abundance based on laser Intensity and smart gain: Medium. Scale bar, 20 μm.
-
Immunohistochemistry was performed on paraffin-embedded human pancreatic adenocarcinoma using integrin subunit alpha V antibody. Antigen retrieval was done in sodium citrate buffer (pH 6.0). DAB was used for detection, with hematoxylin counterstaining. Images were acquired using a Nikon Ci-L Plus microscope (40× objective). Scale bar: 25 μm.
-
Immunohistochemistry was performed on paraffin-embedded mouse kidney using integrin subunit alpha V antibody. Antigen retrieval was done in sodium citrate buffer (pH 6.0). DAB was used for detection, with hematoxylin counterstaining. Images were acquired using a Nikon Ci-L Plus microscope (40× objective). Scale bar: 25 μm.
-
Western blotting analysis using integrin subunit alpha V antibody. Total cell lysates (30 μg) from various cell lines were loaded and separated by SDS-PAGE. The blot was incubated with integrin subunit alpha V antibody and HRP-conjugated goat anti-rabbit secondary antibody respectively.
-
-
其他:
產品詳情
-
Uniprot No.:
-
基因名:
-
別名:ITGAV; Integrin Subunit Alpha V; CD51; MSK8; VNRA; VTNR; Integrin, Alpha V (Vitronectin Receptor, Alpha Polypeptide, Antigen CD51); Antigen Identified By mAb L230; Vitronectin Receptor Subunit Alpha; Vitronectin Receptor; Integrin Alpha-V; Integrin AlphaVbeta3; Integrin, Alpha V; CD51 Antigen
-
反應種屬:Human, Mouse, Rat
-
免疫原:A synthesized peptide derived from Human ITGAV protein
-
免疫原種屬:Homo sapiens (Human)
-
標記方式:Non-conjugated
-
克隆類型:Monoclonal
-
抗體亞型:Rabbit IgG
-
純化方式:Affinity-chromatography
-
克隆號:14C5
-
濃度:It differs from different batches. Please contact us to confirm it.
-
保存緩沖液:Rabbit IgG in PBS (pH 7.4) containing 50% glycerol, and 0.02% sodium azide.
-
產品提供形式:Liquid
-
應用范圍:ELISA, WB, FC, ICC, IHC
-
推薦稀釋比:
Application Recommended Dilution WB 1:1000-1:5000 FC 1:200-1:2000 ICC 1:100-1:1000 IHC 1:50-1:100 -
Protocols:
-
儲存條件:Upon receipt, store at -20°C or -80°C. Avoid repeated freeze.
-
貨期:Basically, we can dispatch the products out in 1-3 working days after receiving your orders. Delivery time maybe differs from different purchasing way or location, please kindly consult your local distributors for specific delivery time.
-
用途:For Research Use Only. Not for use in diagnostic or therapeutic procedures.
相關產品
靶點詳情
-
功能:The alpha-V (ITGAV) integrins are receptors for vitronectin, cytotactin, fibronectin, fibrinogen, laminin, matrix metalloproteinase-2, osteopontin, osteomodulin, prothrombin, thrombospondin and vWF. They recognize the sequence R-G-D in a wide array of ligands. ITGAV:ITGB3 binds to fractalkine (CX3CL1) and may act as its coreceptor in CX3CR1-dependent fractalkine signaling. ITGAV:ITGB3 binds to NRG1 (via EGF domain) and this binding is essential for NRG1-ERBB signaling. ITGAV:ITGB3 binds to FGF1 and this binding is essential for FGF1 signaling. ITGAV:ITGB3 binds to FGF2 and this binding is essential for FGF2 signaling. ITGAV:ITGB3 binds to IGF1 and this binding is essential for IGF1 signaling. ITGAV:ITGB3 binds to IGF2 and this binding is essential for IGF2 signaling. ITGAV:ITGB3 binds to IL1B and this binding is essential for IL1B signaling. ITGAV:ITGB3 binds to PLA2G2A via a site (site 2) which is distinct from the classical ligand-binding site (site 1) and this induces integrin conformational changes and enhanced ligand binding to site 1. ITGAV:ITGB3 and ITGAV:ITGB6 act as a receptor for fibrillin-1 (FBN1) and mediate R-G-D-dependent cell adhesion to FBN1. Integrin alpha-V/beta-6 or alpha-V/beta-8 (ITGAV:ITGB6 or ITGAV:ITGB8) mediates R-G-D-dependent release of transforming growth factor beta-1 (TGF-beta-1) from regulatory Latency-associated peptide (LAP), thereby playing a key role in TGF-beta-1 activation. ITGAV:ITGB3 act as a receptor for CD40LG.; (Microbial infection) Integrin ITGAV:ITGB5 acts as a receptor for Adenovirus type C.; (Microbial infection) Integrin ITGAV:ITGB5 and ITGAV:ITGB3 act as receptors for Coxsackievirus A9 and B1.; (Microbial infection) Integrin ITGAV:ITGB3 acts as a receptor for Herpes virus 8/HHV-8.; (Microbial infection) Integrin ITGAV:ITGB6 acts as a receptor for herpes simplex 1/HHV-1.; (Microbial infection) Integrin ITGAV:ITGB3 acts as a receptor for Human parechovirus 1.; (Microbial infection) Integrin ITGAV:ITGB3 acts as a receptor for West nile virus.; (Microbial infection) In case of HIV-1 infection, the interaction with extracellular viral Tat protein seems to enhance angiogenesis in Kaposi's sarcoma lesions.
-
基因功能參考文獻:
- Binding of small molecule ligands and radiolabelled RGD peptides is modulated by expression and activation status of alphavbeta3 integrin. PMID: 28695371
- There is no difference in the expression of Integrin alphavbeta3 between tumor samples from glioblastomas patients with methylated or unmethylated promoter regions in the (6)O-methylguanine methyltransferase (MGMT). Further analysis of the integrin subunits via ELISA from histologic sections revealed that there is no difference in integrin subunit expression between these patients. PMID: 29882028
- These data suggested CD51 was a predictor for the prognosis of esophageal squamous cell carcinoma patients PMID: 30049512
- This study shows that the D2A sequence of the UPAR induces cell growth through alphaVbeta3 integrin and EGFR. PMID: 29184982
- Cyclin D1b markedly amplified integrin alphavbeta3 expression, which was further up-regulated under lipopolysaccharide stimulation. PMID: 30074214
- differential expression of alphavbeta3 and alphavbeta6 was examined in MDA-MB-231, MDA-MB-468 and MCF-10A cells, which signify three different stages of breast cancer development from highly metastatic to non-tumorigenic stage. PMID: 29577899
- High expression of Integrin alphaVbeta6 is an important cause of active proliferation and impaired apoptosis in cervical cancer. PMID: 28682441
- The results of the present study suggest that the traditional Chinese formula WD3 may inhibit gastric tumor growth, potentially via the downregulation of integrin alphav beta3 and the inhibition of ERK1/2 phosphorylation in vivo PMID: 29152665
- of AIM-cleavage and resulting functional modification could be the basis for designing safe and efficient AIM therapy for various diseases PMID: 27929116
- show that sCD40L/alpha5beta1 interaction leads to platelet activation as evaluated in the human whole blood PMID: 26719354
- Among Greek and Polish patients with intracerebral hemorrhage, the rs7565633 tag SNP of the ITGAV gene was independently associated with the risk of lobar ICH in a codominant model of inheritance. PMID: 27476161
- Although Mn(2+) potently activates other integrins and increases affinity of alphaVbeta6 for pro-TGF-beta1 25- to 55-fold, it increases alphaVbeta8 affinity only 2- to 3-fold. PMID: 28484027
- ITGAVITGAVITGAV PMID: 27363302
- This work identifies that therapeutic targeting of integrins containing an alpha V integrin unit inhibits cancer progression and thus may be of clinical benefit. PMID: 28314844
- this study uncovers a novel pathway by which the TGFbeta-activating integrin alphavbeta8 is expressed in the human intestine on dendritic cell subsets, which is upregulated in patients with inflammatory bowel disease PMID: 27782111
- Integrin alphavbeta3 has a role in enhancing beta-catenin signaling in acute myeloid leukemia harboring Fms-like tyrosine kinase-3 internal tandem duplication mutations PMID: 27248172
- BKCa has a role in promoting growth and metastasis of prostate cancer through facilitating the coupling between alphavbeta3 integrin and FAK PMID: 27233075
- Inhibition of S. aureus ClfA binding to endothelial cell alphaV beta3 by cilengitide prevents endothelial dysfunction PMID: 27606892
- Data show that sulfatide promoted integrin alphaV(ITGAV) expression and stimulated integrin alphaVbeta3 clustering and signaling in hepatocellular carcinoma (HCC) cells. PMID: 27145276
- in shENO1 pancreatic ductal adenocarcinoma (PDA) cells, downregulation of proteins involved in cell-cell and cell-matrix adhesion include alpha v/beta 3 integrin PMID: 28086938
- Low integrin alphaVbeta3 expression is associated with glioblastoma. PMID: 26918452
- Data show that FGF2 mutants have potential as anti-angiogenic agents and useful tools for studying the role of integrin alphavbeta3 in FGF2 signalling. PMID: 28302677
- VANGL2 interacts with Integrin alphaVbeta3 to regulate matrix metalloproteinase activity and cell adhesion to the extracellular matrix. PMID: 29097183
- The results indicate that shear stress is an important mediator in endothelial progenitor cells expression of CD59 regulated by the extacellular matrix-integrin alphaVbeta3-F-actin pathway, which is a key factor in preventing membrane attack complex-mediated cell autolysis. PMID: 28943429
- The mechanism of resistance of tongue squamous carcinoma cells Cal27 with de novo integrin alphavbeta3 expression to anticancer drugs was studied. In Cal27 cells integrin alphav heterodimers signal through pSrc(Y418) while this is not the case in integrin alphavbeta3-expressing cells. PMID: 27108184
- data demonstrate that M. tuberculosis stimulation upregulates integrin alphaVbeta3 expression on monocytes, which upregulates secretion of MMP-1 and -10 on adhesion to the extracellular matrix; this leads to increased monocyte recruitment and collagenase activity, which will drive inflammatory tissue damage PMID: 28646039
- The synergy of circulating factor suPAR and APOL1 G1 or G2 on alphavbeta3 integrin activation is a mechanism for CKD. PMID: 28650456
- overexpression of syndecan-1 confers to B-LCs an increased capacity to migrate in response to Tat, owing to a switch from a CXCR4/G-protein/Rac to a syndecan-1/alphavbeta3/pp60src/pp125FAK signal transduction pathway that depends on the formation of a complex in which syndecan-1 interacts with Tat via its HS-chains, with alphavbeta3 via its core protein ectodomain and with pp60src via its intracellular tail PMID: 27819680
- These results indicate that CD51 is a novel functional marker for colorectal CSCs which may provide an therapeutic target for the efficient elimination of colorectal CSCs. PMID: 27593923
- promoting differentiation of luminal A breast cancer cells by signaling emanating from Int-alphavbeta3 can potentially promote 'normalization' of their malignant phenotype and may prevent the malignant cells from progressing. PMID: 27906177
- Data show that dendritic cells (DCs) induced Th17 cell differentiation through miR-363/Integrin alphav/TGF-beta pathway in patients with rheumatoid arthritis (RA). PMID: 28376277
- Myocardial alphavbeta3 integrin expression represents a marker of ongoing cardiac repair following acute myocardial infarction. PMID: 27927700
- integrin alphaVbeta6 binds pro-TGF-beta1 in an orientation biologically relevant for force-dependent release of TGF-beta from latency PMID: 28117447
- In vitro binding assays with purified components reveal that Tie-integrin recognition is direct, and further demonstrate that the receptor binding domain of the Tie2 ligand Ang-1, but not the receptor binding domain of Ang-2, can independently associate with a5b1 or aVb3. cooperative Tie/integrin interactions selectively stimulate ERK/MAPK signaling in the presence of both Ang-1 and fibronectin PMID: 27695111
- The findings suggest that, in contrast with previous models, the ligand-binding site of integrin alphaVbeta3, binds to the constant region (helices A and B) of the EC2 domain of CD9, CD81, and CD151 antigens. PMID: 27993971
- Antiendothelial alphavbeta3 antibodies are a major cause of intracranial bleeding in fetal/neonatal alloimmune thrombocytopenia. PMID: 27283740
- Integrin alphav is required for local activation of latent TGFbeta, and the wound healing defect in the setting of integrin alphav loss was rescued by exogenous, active TGFbeta. PMID: 27295308
- Taken together, our findings suggested that HMGB1 enhances tumor cell migration ability by activating alphavbeta3/FAK through TLR4/NF-kappaB signaling, leading to metastasis of NSCLC. PMID: 27769864
- these results show that differences in stiffness/fluidity due to alphavbeta3 integrin expression or integrin activation by Mn(2+) might not simply be explained by the coupling of integrins to actin via focal adhesions. PMID: 27553273
- Thus, the alphaV integrin subunit is important for varicella-zoster virus gB/gH-gL-mediated viral membrane fusion and infection. PMID: 27279620
- The blockage of alphavbeta3 integrin inhibited the FAK-Src association and VEGFR activation, thus reducing tubulogenesis. PMID: 27420801
- in some cell lines the cellular entry of human parechovirus 1(HPeV-1) is primarily mediated by the active form of alphaVbeta1 integrin without visible receptor clustering PMID: 27128974
- The results implied that these five single nucleotide polymorphisms in the integrin alphavbeta3 gene were not associated with hemorrhagic fever with renal syndrome susceptibility or severity in Han Chinese individuals in Hubei Province. PMID: 28190175
- Gastric cancer patients who were both alphavbeta6 and MMP-9 positive had a shorter overall survival. PMID: 27076771
- The results of this study demonstrate that molecular dynamics of alphav integrin-GFP can be imaged in lung metastasis, which will allow further understanding of the role of alphav integrin in this process. PMID: 27466481
- Periostin expression in human periodontal ligament fibroblasts promotes the migration of human mesenchymal stem cells through the alphavbeta3 integrin/FAK/PI3K/Akt pathway in vitro. PMID: 25900259
- Results showed that CD51 expression in pancreatic cancer stroma is associated with enhanced tumor malignancy. PMID: 26846197
- endothelial VEGFR-2 appeared to be slightly superior to endothelial alpha v ss 3 for differentiating benign from cancerous lesions. PMID: 26902100
- Identify integrin alphavbeta3 as a receptor ofNC1 domain of collagen XIX. NC1(XIX) inhibits the FAK/PI3K/Akt/mTOR pathway, by decreasing the phosphorylation and activity of the major proteins involved in this pathway. PMID: 26621838
- In this study, the long binding helix of this ligand was downsized to an enzymatically stable cyclic peptide endowed with sub-nanomolar binding affinity toward the alphavbeta6 receptor and remarkable selectivity against other integrins PMID: 26663660
顯示更多
收起更多
-
亞細胞定位:Cell membrane; Single-pass type I membrane protein. Cell junction, focal adhesion.
-
蛋白家族:Integrin alpha chain family
-
數據庫鏈接:
Most popular with customers
-
-
YWHAB Recombinant Monoclonal Antibody
Applications: ELISA, WB, IHC, IF, FC
Species Reactivity: Human, Mouse, Rat
-
Phospho-YAP1 (S127) Recombinant Monoclonal Antibody
Applications: ELISA, WB, IHC
Species Reactivity: Human
-
-
-
-
-